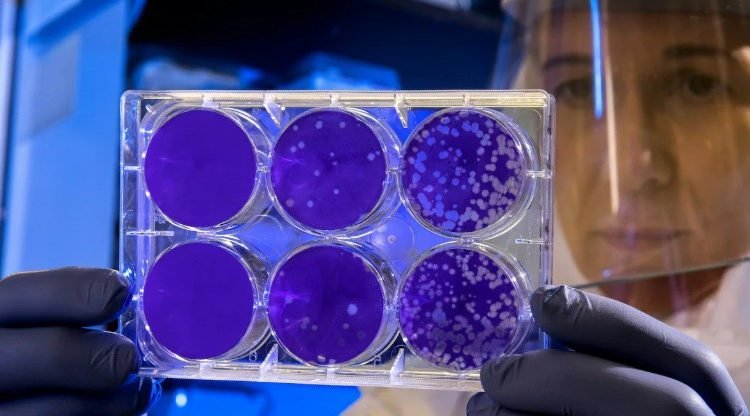

Lancet Study Warns of AMR Crisis in India: 83% Patients Carry Resistant Bacteria
Study reveals 83% of hospitalized patients in India carry drug-resistant bacteria, raising alarm over antibiotic misuse and the growing threat of superbugs.
India is confronting a major public health challenge as research warns of a potential “superbug explosion” driven by widespread antibiotic misuse. A study published in The Lancet during Antimicrobial Awareness Week has revealed alarming levels of drug-resistant infections among hospitalized patients.
Alarming Drug-Resistant Infection Rates
The study highlights that 83% of patients admitted to hospitals in India are already infected with drug-resistant bacteria, a number far higher than Italy (31.5%), the US (20%), and the Netherlands (10.8%). Conducted by AIG Hospitals, Hyderabad, the research analyzed 1,200 patients across four countries, showing that Indian patients are particularly vulnerable, especially those with chronic lung disease, cardiac problems, or repeated antibiotic exposure.
Specialists warn that if antimicrobial resistance (AMR) continues unchecked, common infections could become untreatable, threatening surgeries, cancer therapies, and other critical medical treatments.
Causes Behind the Surge
Physicians attribute the rise in AMR in India to several factors:
-
Easy access to antibiotics without prescriptions.
-
Over-the-counter medications being dispensed without proper guidance.
-
Unregulated use of antibiotics in dairy, poultry, and agriculture.
“The crisis would not be escalating at such a pace if antibiotics were not treated as common medicines,” health professionals stressed.
Government Response and National Action Plan
During the inauguration of the second phase (2025-29) of the National Action Plan on AMR, Union Health Minister JP Nadda highlighted the seriousness of the threat.
“Antimicrobial resistance is a serious challenge to public health. Its resolution is through collective effort,” Nadda said, urging stricter regulation of antimicrobial sales and more public awareness campaigns.
Experts Urge Immediate Action
Experts emphasize that India has the potential to lead the global fight against AMR, but failure to act could turn infections into silent killers, severely burdening the healthcare system. They call for responsible antibiotic usage, robust regulations, and proactive awareness programs to curb the looming superbug crisis.

Comments are closed.